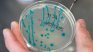
Във Франция откриха Е.coli от същия щам като в Германия

Европейските здравни служби проучват дали заразата с опасната бактерия ешерихия коли в Германия и Франция не може да бъде проследена до семена от сминдух, внесени от Египет или през 2009, или през 2010 г., предаде Асошиейтед прес, цитирана от БТА.
Европейският център за предотвратяване и контрол на заболяванията и Европейската служба за безопасност на храните обявиха в съвместен доклад, че "все още съществува голяма несигурност относно това дали сминдуховите семена са причината за всички случаи на разболели се хора".
Според доклада е възможно доставка от сминдухово семе от 2009 г. да е свързана със заразата във Франция, а друга доставка от 2010 г. - с огнището в Германия.
В текста се признава, че теорията за сминдуховото семе не обяснява смъртния случай в Швеция, където вследствие на зараза с бактерията почина жена, която не е консумирала заразени кълнове.
Световната здравна организация (СЗО) счита заразата във Франция за отделна от тази в Германия, но признава, че от осемте случая във Франция в три е регистриран същият щам, като в Германия.
Това се случи Dnes, за важното през деня ни последвайте и в Google News Showcase.

Meta започва развалянето на сделката с Manus чрез разделяне на дейностите и данните
Meta започва развалянето на сделката с Manus чрез разделяне на дейностите и данните  Столичният общински съвет ще сменя директорите на общинските дружества
Столичният общински съвет ще сменя директорите на общинските дружества  България официално стана част от Европейския механизъм за стабилност
България официално стана част от Европейския механизъм за стабилност  Централната банка на Турция отново остави основните лихви без промяна
Централната банка на Турция отново остави основните лихви без промяна  ОПЕК отново понижи прогнозата си за ръста на глобалното търсене на петрол през 2026 г.
ОПЕК отново понижи прогнозата си за ръста на глобалното търсене на петрол през 2026 г.  Гърция разчита все по-малко на руски и азербайджански газ
Гърция разчита все по-малко на руски и азербайджански газ 
 3 млрд. зрители гледат откриването на Световното по футбол, море от фенове заля Мексико Сити
3 млрд. зрители гледат откриването на Световното по футбол, море от фенове заля Мексико Сити  Oнлайн измами и скиминг: Как крадат данни от банковите ни карти
Oнлайн измами и скиминг: Как крадат данни от банковите ни карти  Радев: Турция е не само съсед и приятел, но и ключов партньор
Радев: Турция е не само съсед и приятел, но и ключов партньор  Медведев: Западът води хибридна война срещу Русия
Медведев: Западът води хибридна война срещу Русия  Полицията спря незаконни гонки с над 200 автомобила в Пазарджик
Полицията спря незаконни гонки с над 200 автомобила в Пазарджик  Масирани проверки на пътя: Спипаха десетки пияни и дрогирани зад волана
Масирани проверки на пътя: Спипаха десетки пияни и дрогирани зад волана 
 Яснота за стадион „Българска армия“: ММС и ЦСКА потвърдиха модела 50:50
Яснота за стадион „Българска армия“: ММС и ЦСКА потвърдиха модела 50:50  Тревожна тенденция в ЦСКА: само трима нови на първата лятна тренировка за последните пет години
Тревожна тенденция в ЦСКА: само трима нови на първата лятна тренировка за последните пет години  Берое пред сериозна криза: Реална опасност да не стартира във Втора лига
Берое пред сериозна криза: Реална опасност да не стартира във Втора лига  Ох, тази жега...
Ох, тази жега...  Историята е против Левски: 4 победи над Дунав на старта, 0 шампионски титли
Историята е против Левски: 4 победи над Дунав на старта, 0 шампионски титли  Мората за Ламин Ямал: Надявам се да стане най-добрият играч на Мондиал 2026
Мората за Ламин Ямал: Надявам се да стане най-добрият играч на Мондиал 2026 
 „Тъмната вещица“ от Нора Робъртс
„Тъмната вещица“ от Нора Робъртс  3 напитки, които стимулират метаболизма веднага след ставане
3 напитки, които стимулират метаболизма веднага след ставане  Сицилиански сладки Rame di Napoli
Сицилиански сладки Rame di Napoli  6 билки и подправки, които са много богати на витамин C
6 билки и подправки, които са много богати на витамин C  6 зодии с много късмет до края на юни
6 зодии с много късмет до края на юни  300 ученици ще гледат на живо тенис събитието на годината благодарение на Postbank и РУО – София-град
300 ученици ще гледат на живо тенис събитието на годината благодарение на Postbank и РУО – София-град 
 продава, Къща, 106 m2 Стара Загора област, гр.Павел Баня, 260000 EUR
продава, Къща, 106 m2 Стара Загора област, гр.Павел Баня, 260000 EUR  продава, Двустаен апартамент, 60 m2 Пловдив, Гагарин, 81972 EUR
продава, Двустаен апартамент, 60 m2 Пловдив, Гагарин, 81972 EUR  продава, Двустаен апартамент, 68 m2 София, Надежда 1, 203000 EUR
продава, Двустаен апартамент, 68 m2 София, Надежда 1, 203000 EUR  продава, Двустаен апартамент, 60 m2 София, Полигона, 180000 EUR
продава, Двустаен апартамент, 60 m2 София, Полигона, 180000 EUR  продава, Едностаен апартамент, 46 m2 Варна област, к.к. Златни Пясъци, 89000 EUR
продава, Едностаен апартамент, 46 m2 Варна област, к.к. Златни Пясъци, 89000 EUR  продава, Къща, 200 m2 София област, с.Голема Раковица, 105000 EUR
продава, Къща, 200 m2 София област, с.Голема Раковица, 105000 EUR 
 Радев: Турция е наш ключов партньор в сигурността, енергетиката и транспортната свързаност
Радев: Турция е наш ключов партньор в сигурността, енергетиката и транспортната свързаност  Два вида измами дебнат любителите на кратките пътувания и удължените уикенди през лятото
Два вида измами дебнат любителите на кратките пътувания и удължените уикенди през лятото  Коцев от Бургас: Всички Черноморски общини трябва да работят заедно
Коцев от Бургас: Всички Черноморски общини трябва да работят заедно  Огромна част от дърво падна до варненско училище и детска градина (СНИМКИ)
Огромна част от дърво падна до варненско училище и детска градина (СНИМКИ)  Проведе се първото заседание за подготовката на „Евровизия 2027“ в България
Проведе се първото заседание за подготовката на „Евровизия 2027“ в България  50 тира паркират протестно по АМ "Хемус" на входа на Варна
50 тира паркират протестно по АМ "Хемус" на входа на Варна 
 Лунен метеорит разкрива историята на три древни сблъсъка
Лунен метеорит разкрива историята на три древни сблъсъка  Могат ли милион сателита с AI да предизвикат хаос в орбита? Мъск не мисли така
Могат ли милион сателита с AI да предизвикат хаос в орбита? Мъск не мисли така  Вулкан в Антарктида изхвърля злато всеки ден
Вулкан в Антарктида изхвърля злато всеки ден  Фосили на 5 млн. години: Откриха най-голямото китово гробище в Индийския океан
Фосили на 5 млн. години: Откриха най-голямото китово гробище в Индийския океан  НАСА представи лунни модули за ключовата мисия „Артемида III“
НАСА представи лунни модули за ключовата мисия „Артемида III“  Климатичните промени застрашават милиони домове в Лондон, Есекс и Кент
Климатичните промени застрашават милиони домове в Лондон, Есекс и Кент 













